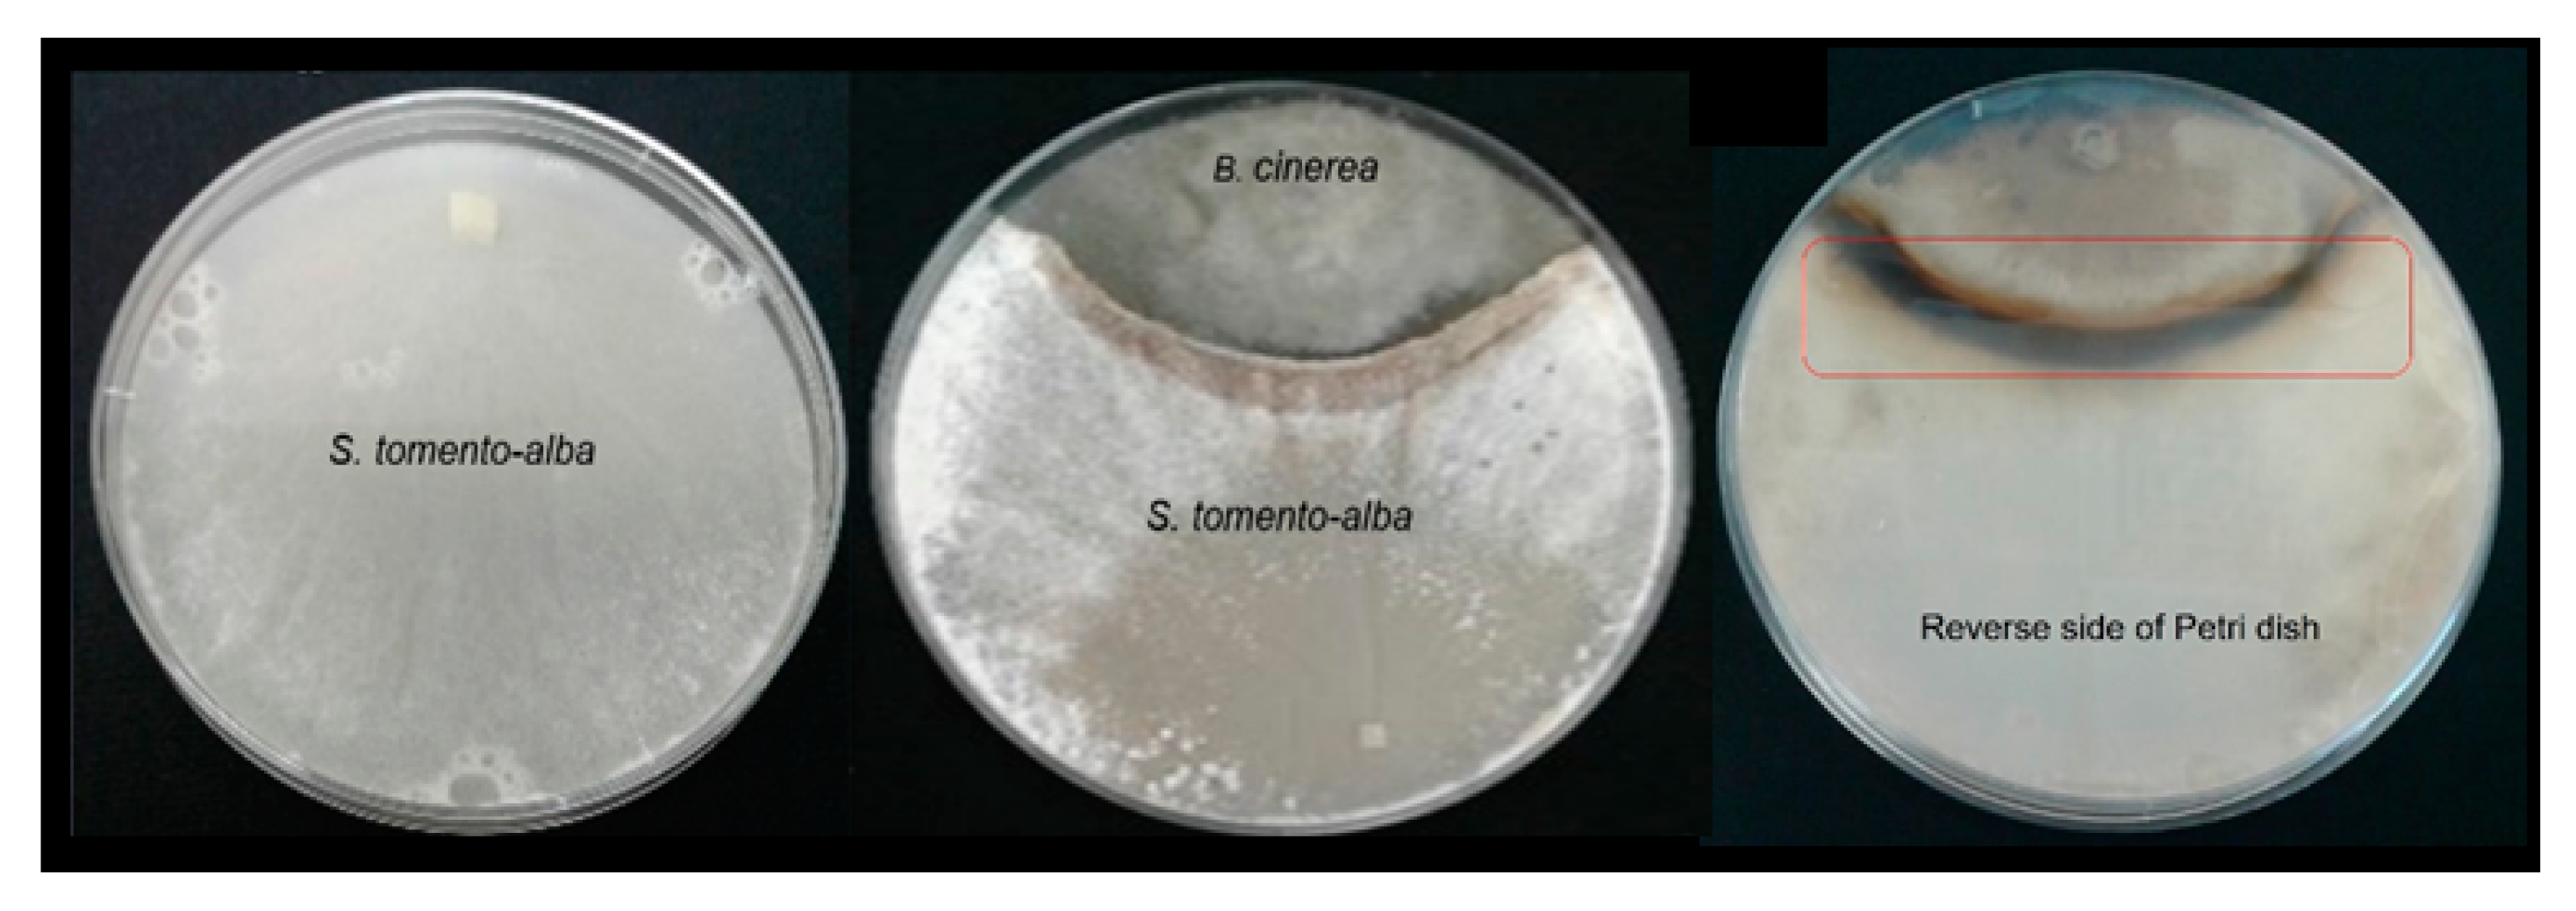
Ijms 25 01022 g003

In Vitro Analysis of the Antagonistic Biological and Chemical Interactions between the Endophyte Sordaria tomento-alba and the Phytopathogen Botrytis cinerea
Abstract
1. Introduction
2. Results
2.1. Isolation and Identification of Endophytic Fungi from Gliricidia sepium
2.2. In Vitro Studies of Antagonistic Activity against Botrytis cinerea
2.2.1. Antagonistic Activity Assay against B. cinerea during Co-Culture
2.2.2. Antifungal Effect of VOCs Produced with S. tomento-alba against B. cinerea
2.3. Metabolite Production during In Vitro Co-Culture
2.3.1. Botryanes Production in Antagonist Test
2.3.2. Metabolites Produced with S. tomento-alba during Co-Cultivation with B05.10
2.4. In Vitro Assessment of Antifungal Activity of Metabolites Produced with S. tomento-alba
2.4.1. Inhibition of B. cinerea Mycelial Growth
2.4.2. Microtiter Plate B. cinerea Spore Germination Assay
3. Discussion
3.1. Endophytic Fungi an Essential Part of the Plant Microbiome
3.2. The Co-Culture of B. cinerea vs. S. tomento-alba
3.3. Metabolites’ Production during Co-Culture
4. Materials and Methods
4.1. Strains and Culture Conditions
4.2. Isolation and Identification of Endophytic Fungi from Gliricidia sepium
4.3. In Vitro Studies of Antagonistic Activity against Botrytis cinerea
4.3.1. Antagonistic Activity Assay against Botrytis cinerea during Co-Culture
4.3.2. Antifungal Effect of VOCs Produced via S. tomento-alba against B. cinerea
4.4. Metabolites Production during Co-Culture
4.4.1. Botryanes Production in Antagonist Test
4.4.2. Metabolites Produced via S. tomento-alba during Co-Cultivation with B. cinerea
4.4.3. Spectroscopic Data for Compounds 3, 6, and 7
- 3′-Episordariol (3): yellow oil, IR (film) νmax 3338, 2974, 2921, 1582, 1468, 1373, 1275, 1075, 977, 789, 754 cm−1; 1H NMR data (CDCl3, 500 MHz) δ 7.16 (t, 1H, J = 7.8 Hz, H-4), 6.97 (dd, 1H, J = 7.8, 1.1 Hz, H-5), 6.85 (d, 1H, J = 15.7 Hz, H-1′), 6.83 (d(superimposed), 1H, J = 7.9 Hz, H-3), 6.1 (dd, 1H, J = 15.7, 6.6 Hz, H-2′), 5.0 (s, 2H, H-7), 4.3 (s (br), 1H, H-3′), 4.0 (dd(br), 1H, J = 6.4, 3.6 Hz, H-4′)), 1.20 (d, 3H, J = 6.5 Hz, H-5′). 13C NMR (CDCl3, 125 MHz) δ 156.5 (C, C-2), 136.2 (C, C-6), 131.0 (CH, C-2′), 129.6 (CH, C-1′), 129.1 (CH, C-4), 121.8 (C- C-1), 118.9 (CH, C-5), 116.2 (CH, C-3), 76.2 (CH, C-3′), 70.3 (CH, C-4), 60.2 (CH2, C-7), 17.7(CH3, C-5′). HREIMS m/z 223.0983 [M − H]+ (calcd for C12H15O4, 223.0970).
- Sordamentone A (6): oil, IR (film) νmax 3337, 2863.5, 1716, 1628, 1600, 1470, 1371, 1294, 1004, 826, 781, 712 cm−1; 1H NMR (CDCl3, 500 MHz) δ 7.16 (dd, 1H, J = 8.1, 7.4 Hz, H-4), 6.73 (dt, 1H, J = 7.4, 0.7 Hz, H-5), 6.68 (dt, 1H, J = 8.1, 0.7 Hz, H-3), 5.72 (q, 1H, J = 3.6, 2.8 Hz, H-1′), 5.15 (dd, 1H, J = 12.3, 2.8 Hz, H-7a), 5.07 (dt, 1H, J = 12.3, 1.8 Hz, H-7b), 4.27 (q, 1H, J = 7.2 Hz, H-4′), 3.06 (dd, 1H, J = 16.0, 7.8 Hz, H-2′a), 2.86 (dd, 1H, J = 16.0, 4.7 Hz, H-2′b), 1.41 (d, 3H, J = 7.2 Hz, H-5′). 13C NMR (CDCl3, 125 MHz) δ 210.5 (C, C-3′), 150.1 (C, C-2), 143.1 (C, C-6), 129.5 (CH, C-4), 125.3 (C, C-1), 114.4 (CH, C-3), 113.4 (CH, C-5), 80.5 (CH, C-1′), 73.4 (CH, C-4′), 70.8 (CH2, C-7), 44.5 (CH2, C-2′), 19.3 (CH3, C-5′). HREIMS m/z 221.0822 [M − H]+ (calcd for C12H13O4, 221.0814).
- Sordamentone B (7): oil, IR (film) νmax 3337, 2863.5, 1716, 1628, 1600, 1470, 1371, 1294, 1004, 826, 781, 712 cm−1; 1H NMR (CDCl3, 500 MHz) δ 7.167 (dd, 1H, J = 8.0, 7.5 Hz, H-4), 6.75 (d(br), 1H, J = 7.5 Hz, H-5), 6.68 (d(br), 1H, J = 8.0 Hz, H-3), 5.72 (m, 1H, H-1′), 5.15 (dd, 1H, J = 12.3, 2.6, 1.1 Hz, H-7a), 5.07 (dt, 1H, J = 12.3, 2.6 Hz, H-7b), 4.30 (q, 1H, J = 7.1 Hz, H-4′), 2.96 (dd, 1H, J = 16.0, 8.0 Hz, H-2′a), 2.91 (dd, 1H, J = 16.0, 4.4 Hz, H-2′b), 1.38 (d, 3H, J = 7.1 Hz, H-5′). 13C NMR (CDCl3, 125 MHz) δ 210.5 (C, C-3′), 150.1 (C, C-2), 143.1 (C, C-6), 129.5 (CH, C-4), 125.3 (C, C-1), 114.4 (CH, C-3), 113.4 (CH, C-5), 80.5 (CH, C-1′), 73.4 (CH, C-4′), 70.8 (CH2, C-7), 44.5 (CH2, C-2′), 19.3 (CH3, C-5′). HREIMS m/z 221.0825 [M − H]+ (calcd for C12H13O4, 221.0814).
4.5. In Vitro Assessment of Antifungal Activity of Metabolites Produced with S. tomento-alba
4.5.1. Inhibition of B. cinerea Mycelial Growth
4.5.2. Microtiter Plate B. cinerea Spore Germination Assay
4.6. Statistical Analysis
5. Conclusions
Supplementary Materials
Author Contributions
Funding
Institutional Review Board Statement
Informed Consent Statement
Data Availability Statement
Conflicts of Interest
References
- Elad, Y.; Vivier, M.; Fillinger, S. Botrytis, The Good, the Bad and the Ugly. In Botrytis—The Fungus, the Pathogen and Its Management in Agricultural Systems; Sabine, F., Yigal, E., Eds.; Springer International Publishing: London, UK, 2016; pp. 1–15. ISBN 978-3-319-23371-0. [Google Scholar]
- Staats, M.; Van Baarlen, P.; Van Kan, J.A.L. Molecular Phylogeny of the Plant Pathogenic Genus Botrytis and the Evolution of Host Specificity. Mol. Biol. Evol. 2005, 22, 333–346. [Google Scholar] [CrossRef] [PubMed]
- Haidar, R.; Fermaud, M.; Calvo-Garrido, C.; Roudet, J.; Deschamps, A. Modes of Action for Biological Control of Botrytis cinerea by Antagonistic Bacteria. Phytopathol. Mediterr. 2016, 55, 13–34. [Google Scholar] [CrossRef]
- Elad, Y.; Pertot, I.; Cotes, A.; Stewart, A. Plant Hosts of Botrytis spp. In Botrytis—The Fungus, the Pathogen and Its Management in Agricultural Systems; Fillinger, S., Elad, Y., Eds.; Springer International Publishing: Cham, Switzerland, 2016; pp. 413–486. [Google Scholar]
- Dean, R.; Van Kan, J.A.L.; Pretorius, Z.A.; Hammond-Kosack, K.E.; Di Pietro, A.; Spanu, P.D.; Rudd, J.J.; Dickman, M.; Kahmann, R.; Ellis, J.; et al. The Top 10 Fungal Pathogens in Molecular Plant Pathology. Mol. Plant Pathol. 2012, 13, 414–430. [Google Scholar] [CrossRef] [PubMed]
- Nicot, P.; Stewart, A.; Bardin, M.; Elad, Y. Biological Control and Biopesticide Suppression of Botrytis-Incited Diseases. In Botrytis—The Fungus, the Pathogen and Its Management in Agricultural Systems; Fillinger, S., Elad, Y., Eds.; Springer: New York, NY, USA, 2016; pp. 165–187. [Google Scholar]
- Abbey, J.A.; Percival, D.; Abbey, L.; Asiedu, S.K.; Prithiviraj, B.; Schilder, A. Biofungicides as Alternative to Synthetic Fungicide Control of Grey Mould (Botrytis cinerea)–Prospects and Challenges. Biocontrol Sci. Technol. 2019, 29, 241–262. [Google Scholar] [CrossRef]
- Dewey, F.; Grant-Dowton, R. Botrytis-Biology, Detection and Quantification. In Botrytis—The Fungus, the Pathogen and Its Management in Agricultural Systems; Fillinger, S., Yigal, E., Eds.; Springer International Publishing: Cham, Switzerland, 2016; pp. 17–34. [Google Scholar]
- Bolívar-Anillo, H.J.; Garrido, C.; Collado, I.G. Endophytic Microorganisms for Biocontrol of the Phytopathogenic Fungus Botrytis cinerea. Phytochem. Rev. 2019, 19, 721–740. [Google Scholar] [CrossRef]
- Rossi, F.R.; Gárriz, A.; Marina, M.; Romero, F.M.; Gonzalez, M.E.; Collado, I.G.; Pieckenstain, F.L. The Sesquiterpene Botrydial Produced by Botrytis cinerea Induces the Hypersensitive Response on Plant Tissues and Its Action Is Modulated by Salicylic Acid and Jasmonic Acid Signaling. Mol. Plant-Microbe Interact. 2011, 24, 888–896. [Google Scholar] [CrossRef] [PubMed]
- Moraga, J.; Izquierdo-Bueno Reina, I.; Pinedo, C.; Hernández-Galán, R.; Viaud, M.; Collado, I.G. Impairment of Botrydial Production in Botrytis cinerea Allows the Isolation of Undescribed Polyketides and Reveals New Insights into the Botcinins Biosynthetic Pathway. Phytochemistry 2021, 183, 112627. [Google Scholar] [CrossRef]
- Collado, I.; Viaud, M. Secondary Metabolism in Botrytis cinerea: Combining Genomic and Metabolomic Approaches. In Botrytis—The Fungus, the Pathogen and Its Management in Agricultural Systems; Fillinger, S., Elad, Y., Eds.; Springer: Cham, Switzerland, 2016; pp. 291–313. [Google Scholar]
- Vignatti, P.; Gonzalez, M.E.; Jofré, E.C.; Bolívar-Anillo, H.J.; Moraga, J.; Viaud, M.; Collado, I.G.; Pieckenstain, F.L. Botrydial Confers Botrytis cinerea the Ability to Antagonize Soil and Phyllospheric Bacteria. Fungal Biol. 2020, 124, 54–64. [Google Scholar] [CrossRef]
- Bolivar-Anillo, H.J.; González-Rodríguez, V.E.; Cantoral, J.M.; García-Sánchez, D.; Collado, I.G.; Garrido, C. Endophytic Bacteria Bacillus subtilis, Isolated from Zea mays, as Potential Biocontrol Agent against Botrytis cinerea. Biology 2021, 10, 20–40. [Google Scholar] [CrossRef]
- Kim, K.H.; Kabir, E.; Jahan, S.A. Exposure to Pesticides and the Associated Human Health Effects. Sci. Total Environ. 2017, 575, 525–535. [Google Scholar] [CrossRef]
- Petit, A.N.; Fontaine, F.; Vatsa, P.; Clément, C.; Vaillant-Gaveau, N. Fungicide Impacts on Photosynthesis in Crop Plants. Photosynth. Res. 2012, 111, 315–326. [Google Scholar] [CrossRef]
- Pirttilä, A.M.; Tabas, H.M.P.; Baruah, N.; Koskimäki, J.J. Biofertilizers and Biocontrol Agents for Agriculture: How to Identify and Develop New Potent Microbial Strains and Traits. Microorganisms 2021, 9, 817. [Google Scholar] [CrossRef]
- Meena, R.S.; Kumar, S.; Datta, R.; Lal, R.; Vijayakumar, V.; Brtnicky, M.; Sharma, M.P.; Yadav, G.S.; Jhariya, M.K.; Jangir, C.K.; et al. Impact of Agrochemicals on Soil Microbiota and Management: A Review. Land 2020, 9, 34. [Google Scholar] [CrossRef]
- Raymaekers, K.; Ponet, L.; Holtappels, D.; Berckmans, B.; Cammue, B.P.A. Screening for Novel Biocontrol Agents Applicable in Plant Disease Management—A Review. Biol. Control 2020, 144, 104240. [Google Scholar] [CrossRef]
- Suryanarayanan, T.; Rajulu, G.; Vidal, S. Biological Control Through Fungal Endophytes: Gaps In Knowledge Hindering Success. Curr. Biotechnol. 2018, 7, 185–198. [Google Scholar] [CrossRef]
- Lu, X.H.; Jiao, X.L.; Hao, J.J.; Chen, A.J.; Gao, W.W. Characterization of Resistance to Multiple Fungicides in Botrytis cinerea Populations from Asian Ginseng in Northeastern China. Eur. J. Plant Pathol. 2016, 144, 467–476. [Google Scholar] [CrossRef]
- Syed Ab Rahman, S.F.; Singh, E.; Pieterse, C.M.J.; Schenk, P.M. Emerging Microbial Biocontrol Strategies for Plant Pathogens. Plant Sci. 2018, 267, 102–111. [Google Scholar] [CrossRef] [PubMed]
- Glare, T.; Caradus, J.; Gelernter, W.; Jackson, T.; Keyhani, N.; Köhl, J.; Marrone, P.; Morin, L.; Stewart, A. Have Biopesticides Come of Age? Trends Biotechnol. 2012, 30, 250–258. [Google Scholar] [CrossRef]
- Pal, K.; Gardener, B. Biological Control of Plant Pathogens. Plant Health Instr. 2006, 1–25. [Google Scholar] [CrossRef]
- Bardin, M.; Ajouz, S.; Comby, M.; Lopez-Ferber, M.; Graillot, B.; Siegwart, M.; Nicot, P.C. Is the Efficacy of Biological Control against Plant Diseases Likely to Be More Durable than That of Chemical Pesticides? Front. Plant Sci. 2015, 6, 566. [Google Scholar] [CrossRef]
- Lazarovits, G.; Turnbull, A.; Johnston-Monje, D. Plant Health Management: Biological Control of Plant Pathogens; Elsevier Ltd.: Amsterdam, The Netherlands, 2014; Volume 4, ISBN 9780080931395. [Google Scholar]
- Le Cocq, K.; Gurr, S.; Hirsch, P.; Mauchline, T. Exploitation of Endophytes for Sustainable Agricultural Intensification. Mol. Plant Pathol. 2017, 18, 469–473. [Google Scholar] [CrossRef] [PubMed]
- Ludwig-Müller, J. Plants and Endophytes: Equal Partners in Secondary Metabolite Production? Biotechnol. Lett. 2015, 37, 1325–1334. [Google Scholar] [CrossRef] [PubMed]
- Krings, M.; Taylor, T.N.; Hass, H.; Kerp, H.; Dotzler, N.; Hermsen, E.J. Fungal Endophytes in a 400-Million-Yr-Old Land Plant: Infection Pathways, Spatial Distribution, and Host Responses. New Phytol. 2007, 174, 648–657. [Google Scholar] [CrossRef] [PubMed]
- Suryanarayanan, T.S. Fungal Endophytes: An Eclectic Review. Kavaka 2017, 48, 1–9. [Google Scholar]
- Rodriguez, R.J.; White, J.F., Jr.; Arnold, A.E.; Redman, R.S. Fungal Endophytes: Diversity and Functional Roles: Tansley Review. New Phytol. 2009, 182, 314–330. [Google Scholar] [CrossRef] [PubMed]
- Aly, A.H.; Debbab, A.; Kjer, J.; Proksch, P. Fungal Endophytes from Higher Plants: A Prolific Source of Phytochemicals and Other Bioactive Natural Products. Fungal Divers. 2010, 41, 1–16. [Google Scholar] [CrossRef]
- Segaran, G.; Sathiavelu, M. Fungal Endophytes: A Potent Biocontrol Agent and a Bioactive Metabolites Reservoir. Biocatal. Agric. Biotechnol. 2019, 21, 101284. [Google Scholar] [CrossRef]
- Bertrand, S.; Bohni, N.; Schnee, S.; Schumpp, O.; Gindro, K.; Wolfender, J.L. Metabolite Induction via Microorganism Co-Culture: A Potential Way to Enhance Chemical Diversity for Drug Discovery. Biotechnol. Adv. 2014, 32, 1180–1204. [Google Scholar] [CrossRef]
- Huang, R.; Li, G.Q.; Zhang, J.; Yang, L.; Che, H.J.; Jiang, D.H.; Huang, H.C. Control of Postharvest Botrytis Fruit Rot of Strawberry by Volatile Organic Compounds of Candida intermedia. Phytopathology 2011, 101, 859–869. [Google Scholar] [CrossRef]
- Bouillant, M.L.; Bernillon, J.; Favre-Bonvin, J.; Salin, N. New Hexaketides Related to Sordariol in Sordaria macrospora. Z. Naturforsch.-Sect. C J. Biosci. 1989, 44, 719–723. [Google Scholar] [CrossRef]
- Bouillant, M.L.; Favre-Bonvin, J.; Salin, N.; Bernillon, J. Sordariol and Related Compounds, Hexaketides in the Fungus Sordaria macrospora. Phytochemistry 1988, 27, 1517–1519. [Google Scholar] [CrossRef]
- Li, T.; Wang, X.; Luo, J.; Yang, M.; Kong, L. Antioxidant Sordariol Dimers from Sordaria macrospora and the Absolute Configuration Determinations of Their Two Simultaneous Linear 1,2-Diols. Tetrahedron Lett. 2016, 57, 2754–2757. [Google Scholar] [CrossRef]
- Fujimoto, H.; Sumino, M.; Nagano, J.; Natori, H.; Okuyama, E.; Yamazaki, M. Immunomodulatory Constituents from Three Ascomycetes, Gelasinospora heterospora, G. multiforis, and G. longispora. Chem. Pharm. Bull. 1999, 47, 71–76. [Google Scholar] [CrossRef] [PubMed]
- Wakefield, J.; Hassan, H.M.; Jaspars, M.; Ebel, R.; Rateb, M.E. Dual Induction of New Microbial Secondary Metabolites by Fungal Bacterial Co-Cultivation. Front. Microbiol. 2017, 8, 1284. [Google Scholar] [CrossRef] [PubMed]
- Soliman, S.S.M.; Raizada, M.N. Interactions between Co-Habitating Fungi Elicit Synthesis of Taxol from an Endophytic Fungus in Host Taxus Plants. Front. Microbiol. 2013, 4, 3. [Google Scholar] [CrossRef] [PubMed]
- Serrano, R.; González-Menéndez, V.; Rodríguez, L.; Martín, J.; Tormo, J.R.; Genilloud, O. Co-Culturing of Fungal Strains against Botrytis cinerea as a Model for the Induction of Chemical Diversity and Therapeutic Agents. Front. Microbiol. 2017, 8, 649. [Google Scholar] [CrossRef] [PubMed]
- Rashmi, M.; Kushveer, J.S.; Sarma, V.V. A Worldwide List of Endophytic Fungi with Notes on Ecology and Diversity. Mycosphere 2019, 10, 798–1079. [Google Scholar] [CrossRef]
- Faeth, S.H. Are Endophytic Fungi Defensive Plant Mutualists? Oikos 2002, 98, 25–36. [Google Scholar] [CrossRef]
- Cuervo-Jiménez, A.; Narváez-Solarte, W.; Hahn von-Hessberg, C. Características de la Especie Gliricidia sepium (Jacq.) Stend, FaBaCeae. Bol. Cient. Mus. Hist. Nat. 2013, 17, 33–45. [Google Scholar]
- Park, S.; Ten, L.; Lee, S.Y.; Back, C.G.; Lee, J.J.; Lee, H.B.; Jung, H.Y. New Recorded Species in Three Genera of the Sordariomycetes in Korea. Mycobiology 2017, 45, 64–72. [Google Scholar] [CrossRef]
- Maharachchikumbura, S.S.N.; Hyde, K.D.; Jones, E.B.G.; McKenzie, E.H.C.; Bhat, J.D.; Dayarathne, M.C.; Huang, S.K.; Norphanphoun, C.; Senanayake, I.C.; Perera, R.H.; et al. Families of Sordariomycetes; Springer: Berlin/Heidelberg, Germany, 2016; Volume 79, ISBN 1322501603696. [Google Scholar]
- Yan, J.; Cui, Y.; Ding, J.; Zhou, L.; Cheng, Z.; Zhang, M. Isolation and Identification of the Causal Pathogens for Kiwifruit Bacterial Canker and the Isolation of the Antagonistic Endophytic Fungi From Kiwifruit in Sichuan, China. J. Agric. Sci. 2013, 5, 262–268. [Google Scholar] [CrossRef]
- González, V.; Tello, M.L. The Endophytic Mycota Associated with Vitis vinifera in Central Spain. Fungal Divers. 2011, 47, 29–42. [Google Scholar] [CrossRef]
- De Errasti, A.; Carmarán, C.C.; Novas, M.V. Diversity and Significance of Fungal Endophytes from Living Stems of Naturalized Trees from Argentina. Fungal Divers. 2010, 41, 29–40. [Google Scholar] [CrossRef]
- Malmierca, M.G.; Barua, J.; McCormick, S.P.; Izquierdo-Bueno, I.; Cardoza, R.E.; Alexander, N.J.; Hermosa, R.; Collado, I.G.; Monte, E.; Gutiérrez, S. Novel Aspinolide Production by Trichoderma arundinaceum with a Potential Role in Botrytis cinerea Antagonistic Activity and Plant Defence Priming. Environ. Microbiol. 2015, 17, 1103–1118. [Google Scholar] [CrossRef] [PubMed]
- Liñeiro, E.; Macias-Sánchez, A.J.; Espinazo, M.; Cantoral, J.M.; Moraga, J.; Collado, I.G.; Fernández-Acero, F.J. Phenotypic Effects and Inhibition of Botrydial Biosynthesis Induced by Different Plant-Based Elicitors in Botrytis cinerea. Curr. Microbiol. 2018, 75, 431–440. [Google Scholar] [CrossRef] [PubMed]
- Morath, S.U.; Hung, R.; Bennett, J.W. Fungal Volatile Organic Compounds: A Review with Emphasis on Their Biotechnological Potential. Fungal Biol. Rev. 2012, 26, 73–83. [Google Scholar] [CrossRef]
- Li, Q.; Ning, P.; Zheng, L.; Huang, J.; Li, G.; Hsiang, T. Effects of Volatile Substances of Streptomyces globisporus JK-1 on Control of Botrytis cinerea on Tomato Fruit. Biol. Control 2012, 61, 113–120. [Google Scholar] [CrossRef]
- Soylu, E.M.; Kurt, Ş.; Soylu, S. In Vitro and In Vivo Antifungal Activities of the Essential Oils of Various Plants against Tomato Grey Mould Disease Agent Botrytis cinerea. Int. J. Food Microbiol. 2010, 143, 183–189. [Google Scholar] [CrossRef]
- Martín, J.A.; Macaya-Sanz, D.; Witzell, J.; Blumenstein, K.; Gil, L. Strong in Vitro Antagonism by Elm Xylem Endophytes Is Not Accompanied by Temporally Stable in Planta Protection against a Vascular Pathogen under Field Conditions. Eur. J. Plant Pathol. 2015, 142, 185–196. [Google Scholar] [CrossRef]
- Tsague Tankeu, V.F.; Sema, D.K.; Jouda, J.B.; Tatsimo, S.J.N.; Ntonga, P.A.; Wansi, J.D.; Fogue, S.K.; Loura, B.; Shiono, Y.; Sewald, N.; et al. Heptacyclosordarianone, a New Polyketide From Sordaria sp., an Endophytic Fungus From Garcinia polyantha. Nat. Prod. Commun. 2020, 15, 1934578X20977622. [Google Scholar] [CrossRef]
- Liang, H. Sordarin, an Antifungal Agent with a Unique Mode of Action. Beilstein J. Org. Chem. 2008, 4, 31. [Google Scholar] [CrossRef] [PubMed]
- Charria-Girón, E.; Surup, F.; Marin-Felix, Y. Diversity of Biologically Active Secondary Metabolites in the Ascomycete Order Sordariales. Mycol. Prog. 2022, 21, 43. [Google Scholar] [CrossRef]
- Schulz, B.; Boyle, C.; Draeger, S.; Römmert, A.K.; Krohn, K. Endophytic Fungi: A Source of Novel Biologically Active Secondary Metabolites. Mycol. Res. 2002, 106, 996–1004. [Google Scholar] [CrossRef]
- Romanazzi, G.; Smilanick, J.L.; Feliziani, E.; Droby, S. Integrated Management of Postharvest Gray Mold on Fruit Crops. Postharvest Biol. Technol. 2016, 113, 69–76. [Google Scholar] [CrossRef]
- Lipinski, B.; Hanson, C.; Lomax, J.; Kitinoja, L.; Waite, R.; Searchinger, T. Creating a Sustainable Food Future, Installment Two: Reducing Food Loss and Waste; World Resources Institute: Washington, DC, USA, 2013; Volume 40. [Google Scholar]
- Büttner, P.; Koch, F.; Voigt, K.; Quidde, T.; Risch, S.; Blaich, R.; Brückner, B.; Tudzynski, P. Variations in Ploidy among Isolates of Botrytis cinerea: Implications for Genetic and Molecular Analyses. Curr. Genet. 1994, 25, 445–450. [Google Scholar] [CrossRef] [PubMed]
- Potshangbam, M.; Devi, I.; Sahoo, D.; Strobel, G. Functional Characterization of Endophytic Fungal Community Associated with Oryza sativa L. and Zea mays L. Front. Microbiol. 2017, 8, 325. [Google Scholar] [CrossRef]
- Kusari, P.; Kusari, S.; Spiteller, M.; Kayser, O. Endophytic Fungi Harbored in Cannabis sativa L.: Diversity and Potential as Biocontrol Agents against Host Plant-Specific Phytopathogens. Fungal Divers. 2013, 60, 137–151. [Google Scholar] [CrossRef]
- Izquierdo-Bueno, I.; Moraga, J.; Cardoza, R.E.; Lindo, L.; Hanson, J.R.; Gutiérrez, S.; Collado, I.G. Relevance of the Deletion of the: Tatri4 Gene in the Secondary Metabolome of Trichoderma arundinaceum. Org. Biomol. Chem. 2018, 16, 2955–2965. [Google Scholar] [CrossRef]
- Simionato, A.; Navarro, M.; de Jesus, M.; Barazetti, A.; da Silva, C.; Simoes, G.; Baldi-Peña, M.; Mello, J.; Panagio, L.; de Almeida, R.; et al. The Effect of Phenazine-1-Carboxylic Acid on Mycelial Growth of Botrytis cinerea Produced by Pseudomonas aeruginosa LV Strain. Front. Microbiol. 2017, 8, 1102. [Google Scholar] [CrossRef]
- Aqueveque, P.; Céspedes, C.L.; Alarcón, J.; Schmeda-Hirschmann, G.; Cañumir, J.A.; Becerra, J.; Silva, M.; Sterner, O.; Radrigán, R.; Aranda, M. Antifungal Activities of Extracts Produced by Liquid Fermentations of Chilean Stereum Species against Botrytis cinerea (Grey Mould Agent). Crop Prot. 2016, 89, 95–100. [Google Scholar] [CrossRef]
- Franco, V.; Ruiz, J. V Informe Nacional de La Biodiversidad de Colombia Ante El Convenio de Diversidad Biológica; Instituto Alexander von Humboldt: Bogotá, CO, USA, 2014. [Google Scholar]

| Antagonism Test | % Inhibition |
| Co-culture | 66 |
| Double disc co-culture | 53 |
| Mycelial Growth Inhibition [MGI] | ||||||||||
|---|---|---|---|---|---|---|---|---|---|---|
| [ ] μg·mL−1 | 1 | 5 | 10 | 20 | 25 | 35 | 47 | 70 | 140 | 250 |
| %MGI | 7 | 37 | 47 | 63 | 75 | 79 | 79 | 82 | 84 | 100 |
| Inhibition of Spore Germination | ||||||||
|---|---|---|---|---|---|---|---|---|
| [ ] μg·mL−1 | 5 | 10 | 25 | 35 | 47 | 70 | 140 | 250 |
| % inhibition | 65 | 76 | 83 | 83 | 90 | 96 | 100 | 100 |
| Strains | Species | Origin of Isolate | References |
|---|---|---|---|
| WT:B05.10 | B. cinerea | Vitis vinifera | [63] |
| ST1-UCA | S. tomento-alba | Gliricidia sepium | This study |
Disclaimer/Publisher’s Note: The statements, opinions and data contained in all publications are solely those of the individual author(s) and contributor(s) and not of MDPI and/or the editor(s). MDPI and/or the editor(s) disclaim responsibility for any injury to people or property resulting from any ideas, methods, instructions or products referred to in the content. |
© 2024 by the authors. Licensee MDPI, Basel, Switzerland. This article is an open access article distributed under the terms and conditions of the Creative Commons Attribution (CC BY) license (https://creativecommons.org/licenses/by/4.0/).
Share and Cite
Bolívar-Anillo, H.J.; Izquierdo-Bueno, I.; González-Rey, E.; González-Rodríguez, V.E.; Cantoral, J.M.; Collado, I.G.; Garrido, C. In Vitro Analysis of the Antagonistic Biological and Chemical Interactions between the Endophyte Sordaria tomento-alba and the Phytopathogen Botrytis cinerea. Int. J. Mol. Sci. 2024, 25, 1022. https://doi.org/10.3390/ijms25021022
Bolívar-Anillo HJ, Izquierdo-Bueno I, González-Rey E, González-Rodríguez VE, Cantoral JM, Collado IG, Garrido C. In Vitro Analysis of the Antagonistic Biological and Chemical Interactions between the Endophyte Sordaria tomento-alba and the Phytopathogen Botrytis cinerea. International Journal of Molecular Sciences. 2024; 25(2):1022. https://doi.org/10.3390/ijms25021022
Chicago/Turabian StyleBolívar-Anillo, Hernando José, Inmaculada Izquierdo-Bueno, Estrella González-Rey, Victoria E. González-Rodríguez, Jesús M. Cantoral, Isidro G. Collado, and Carlos Garrido. 2024. "In Vitro Analysis of the Antagonistic Biological and Chemical Interactions between the Endophyte Sordaria tomento-alba and the Phytopathogen Botrytis cinerea" International Journal of Molecular Sciences 25, no. 2: 1022. https://doi.org/10.3390/ijms25021022
APA StyleBolívar-Anillo, H. J., Izquierdo-Bueno, I., González-Rey, E., González-Rodríguez, V. E., Cantoral, J. M., Collado, I. G., & Garrido, C. (2024). In Vitro Analysis of the Antagonistic Biological and Chemical Interactions between the Endophyte Sordaria tomento-alba and the Phytopathogen Botrytis cinerea. International Journal of Molecular Sciences, 25(2), 1022. https://doi.org/10.3390/ijms25021022

